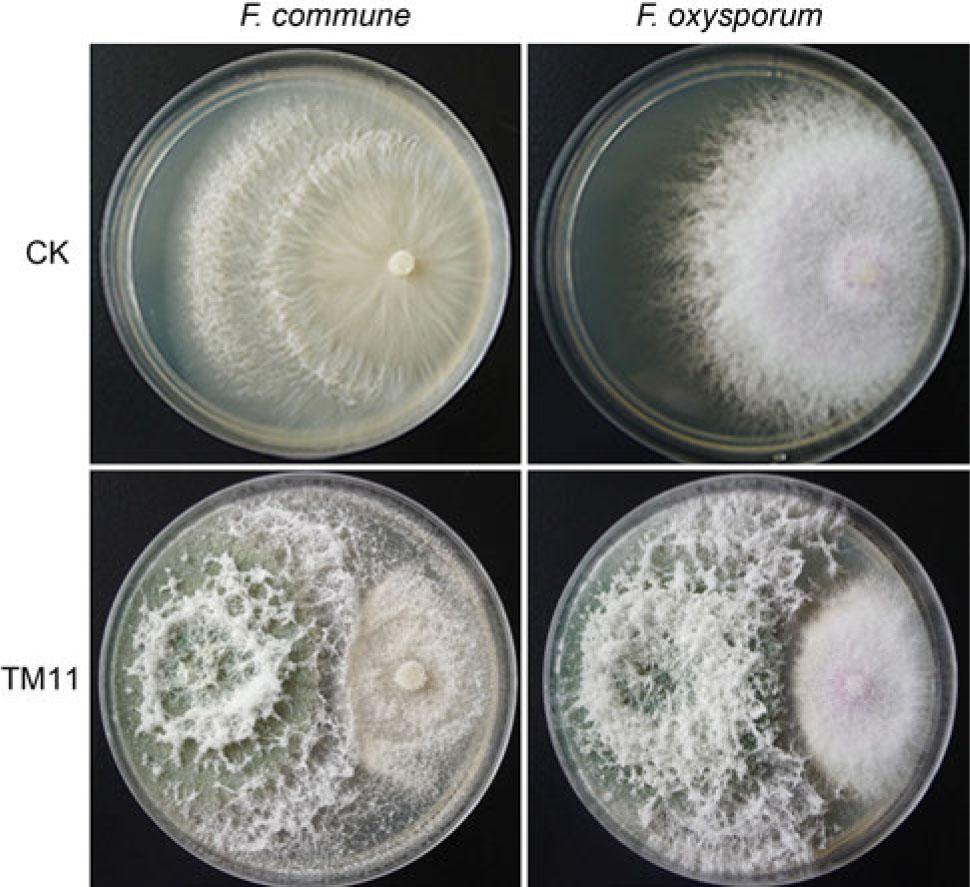
Inhibitory activity of strain TM11 against Fusarium commune and Fusarium oxysporum.CK is F. commune and F. oxysporum alone; on the left side of each plate is the TM11 colony, and on the right side is the colony of F. commune or F. oxysporum.
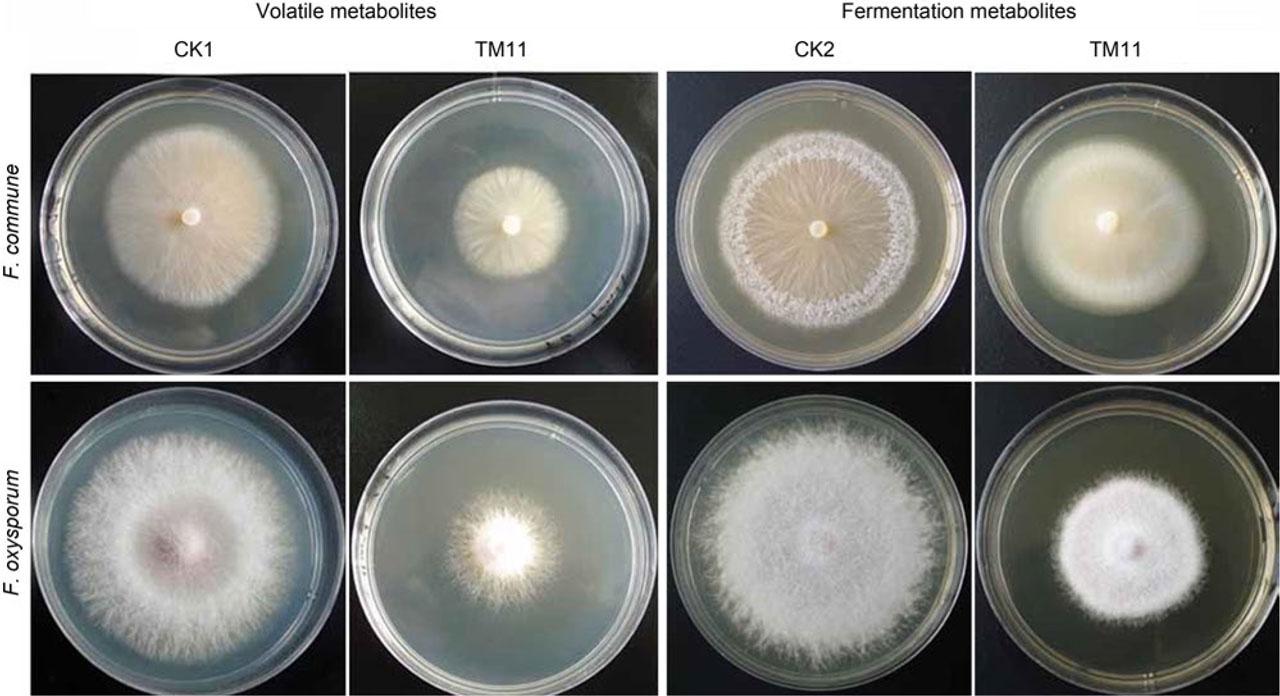
Inhibitory effects of volatile metabolites and fermentation metabolites of Trichoderma asperellum strain TM11 on the growth of Fusarium commune and Fusarum oxysporum.CK1 and CK2 represent the growth of F. commune and F. oxysporum on PDA; volatile metabolites mean volatile organic compounds (VOCs) and fermentation metabolites mean secondary metabolites, including alkaloids, ketones, esters, phenols and organic acids, such as erucamide, dibutyl phthalate and benzophenone.

Fig. 1.
Fig. 2.

Fig. 3.

Fig. 4.

Fig. 5.
Fig. 6.

Inhibitory effects of volatile and fermentation metabolites of Trichoderma asperellum strain TM11 on the growth of Fusarium commune and Fusarium oxysporum_
| Treatment | Fusarium commune | Fusarium oxysporum | ||
|---|---|---|---|---|
| Diameter of pathogen colony (cm) | Percentage inhibition (%) | Diameter of pathogen colony (cm) | Percentage inhibition (%) | |
| CK1 | 5.77 ± 0.05a | n.d. | 5.97 ± 0.05a | n.d. |
| Volatile metabolites | 3.83 ± 0.04b | 33.53 ± 0.72a | 3.77 ± 0.17b | 36.87 ± 2.74a |
| CK2 | 7.00 ± 0.22a | n.d. | 8.87 ± 0.05a | n.d. |
| Fermentation metabolites | 5.83 ± 0.05b | 16.67 ± 2.81b | 5.60 ± 0.08b | 36.84 ± 0.98a |
Types and relative abundances of antimicrobial metabolites produced in culture filtrates by Trichoderma asperellum strain TM11 based on HPLC–MS analysis of methanol extracts of fermentation broth_
| Chemical compound | Peak area | Retention time (min) | m/z |
|---|---|---|---|
| Erucamide | 221862.78 | 7.22 | 338 |
| Dibutyl phthalate | 158594.53 | 6.73 | 279 |
| Benzophenone | 24466.55 | 6.00 | 183 |
| Benzothiazole | 49711.09 | 7.09 | 136 |
| Citric acid | 49252.02 | 1.11 | 193 |
| Betainel | 6165.18 | 0.89 | 118 |
| Dipropyl phthalate | 5286.64 | 6.07 | 251 |
| alpha-Curcumene | 3619.38 | 5.43 | 203 |
| Phenylalanine | 2535.44 | 2.52 | 166 |
| 3-Hydroxycinnamic acid | 2500.47 | 2.90 | 165 |
| Chlorogenic acid | 1903.63 | 3.02 | 355 |
| 4-Hydroxybenzoic acid | 517.80 | 3.16 | 139 |
Effects of inoculation with Trichoderma asperellum strain TM11 and Fusarium commune or Fusarium oxysporum on SOD, POD, and CAT activities in leaf and root tissue of blueberry seedlings_
| Treatment | Leaf | Root | ||||
|---|---|---|---|---|---|---|
| CAT (U/g fresh weight) | SOD (U/g fresh weight) | POD (U/g fresh weight) | CAT (U/g fresh weight) | SOD (U/g fresh weight) | POD (U/g fresh weight) | |
| CK | 128.14 ± 5.86b | 208.01 ± 4.05c | 142.08 ± 4.05d | 140.96 ± 3.30c | 406.44 ± 2.02b | 150.86 ± 3.60d |
| TM11 | 224.59 ± 12.19a | 446.95 ± 3.21a | 353.22 ± 3.37a | 279.22 ± 1.36a | 490.13 ± 1.77a | 363.61 ± 11.14a |
| TM11 + F. commune | 217.09 ± 7.41a | 352.75 ± 4.79b | 309.32 ± 6.20b | 228.79 ± 3.43b | 469.36 ± 4.60a | 313.66 ± 4.75b |
| TM11 + F. oxysporum | 213.37 ± 9.78a | 349.54 ± 4.29b | 205.23 ± 0.30c | 274.70 ± 1.65a | 490.39 ± 12.74a | 306.37 ± 9.38b |
Relative control effect of Trichoderma asperellum strain TM11 against Fusarium commune and Fusarium oxysporum disease in blueberry plants in a pot test after four weeks_
| Treatment | Fusarium commune | Fusarium oxysporum | ||
|---|---|---|---|---|
| Disease index | Percentage disease (%) | Disease index | Percentage disease (%) | |
| Control | 96.00 ± 3.27a | n.d. | 97.33 ± 1.88a | n.d. |
| Inoculation with TM11 first | 6.67 ± 1.89c | 93.05 ± 1.99a | 14.67 ± 1.89c | 84.76 ± 1.57a |
| Inoculation with pathogens first | 28.00 ± 3.27b | 70.92 ± 2.41b | 36.00 ± 3.27b | 62.46 ± 1.28b |
j_pjm-2023-034_tab_006
| Grade 0: | no disease; |
| Grade 1: | diseased spots on the root of blueberry seedlings less than 1.0 cm in size, but the plants were healthy; |
| Grade 2: | blueberry seedling root lesions of 1.0–2.0 cm, seedling leaves slightly withered, and lower leaves rarely shed; |
| Grade 3: | root lesions of blueberry seedlings were more than 2.0 cm, and seedling leaves were withered or fell off; |
| Grade 4: | blueberry seedling showed brown root rot, or the whole plant withered; |
| Grade 5: | blueberry seedling was dead. |
Percentage inhibition of the mycelial colonies of the blueberry root rot pathogens Fusarium commune and Fusarium oxysporum by TM11 compared with the untreated control (CK) assessed in dual culture plates after 5 days of incubation_
| Strain | Fusarium commune | Fusarium oxysporum | ||
|---|---|---|---|---|
| Treatment colony radius (cm) | Percentage inhibition (%) | Treatment colony radius (cm) | Percentage inhibition (%) | |
| CK | 5.42 ± 0.08a | n.d. | 5.53 ± 0.05a | n.d. |
| TM11 | 1.73 ± 0.09b | 68.01 ± 1.45 | 1.90 ± 0.06b | 65.65 ± 1.22 |